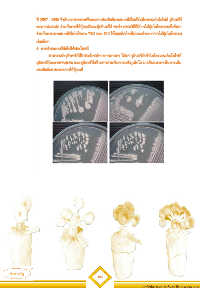

Page 185 - บทคัดย่อการทดลองสิ้นสุด 58 (เลม 1)
P. 185
ปี 2557 - 2558 ซึ่งเป็นการทดลองเพื่อทดสอบประสิทธิภาพแบคทีเรียตรึงไนโตรเจนเอ็นโดไฟท์ จุลินทรีย์
ละลายฟอสเฟต ร่วมกับการใช้ปุ๋ยเคมีและปุ๋ยอินทรีย์ พบว่า กรรมวิธีที่มีการใส่ปุ๋ยไนโตรเจนครึ่งอัตรา
ร่วมกับการเพาะแบคทีเรียไอโซเลท 73I2 และ S10 ให้ผลผลิตอ้อยไม่แตกต่างจากการใส่ปุ๋ยไนโตรเจน
เต็มอัตรา
6. การนำผลงานวิจัยไปใช้ประโยชน์
สามารถนำจุลินทรีย์ที่มีประโยชน์ทางการเกษตร ได้แก่ จุลินทรีย์ตรึงไนโตรเจนเอ็นโดไฟท์
จุลินทรีย์ละลายฟอสเฟต และจุลินทรีย์สร้างสารส่งเสริมการเจริญเติบโต มาเป็นแนวทางในการเพิ่ม
ผลผลิตอ้อย และลดการใช้ปุ๋ยเคมี
161